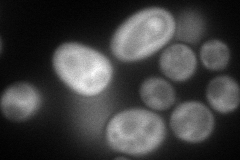
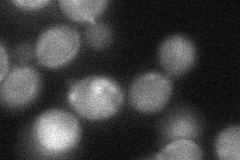
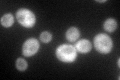

View description
Gamma subunit of the translation initiation factor eIF2B, the guanine-nucleotide exchange factor for eIF2; activity subsequently regulated by phosphorylated eIF2; first identified as a negative regulator of GCN4 expression
Localization:
Intensity:
Fold change:
Significance:
-
C’ GFP library in SD

cytosol75.78 -
N' NOP1pr-GFP in SD
cytosol95.4468 -
N' TEF2pr-mCherry in SD

cytosol86.0244 -
N' NATIVEpr-GFP in SD

below threshold15.5618 -
N' TEF2pr-VC and Cyto-VN in SD
cytosol42.4776 -
C’ GFP library in SD+DTT
cytosol66.210.87No -
C’ GFP library in SD+H2O2

cytosol81.851.08No -
C’ GFP library in Starvation Media

cytosol41.10.54No -
C’ GFP library on the background of Pup2-DaMP

cytosol -
C’ GFP library on the background of CCT mutant

cytosol81.32241.07298No
